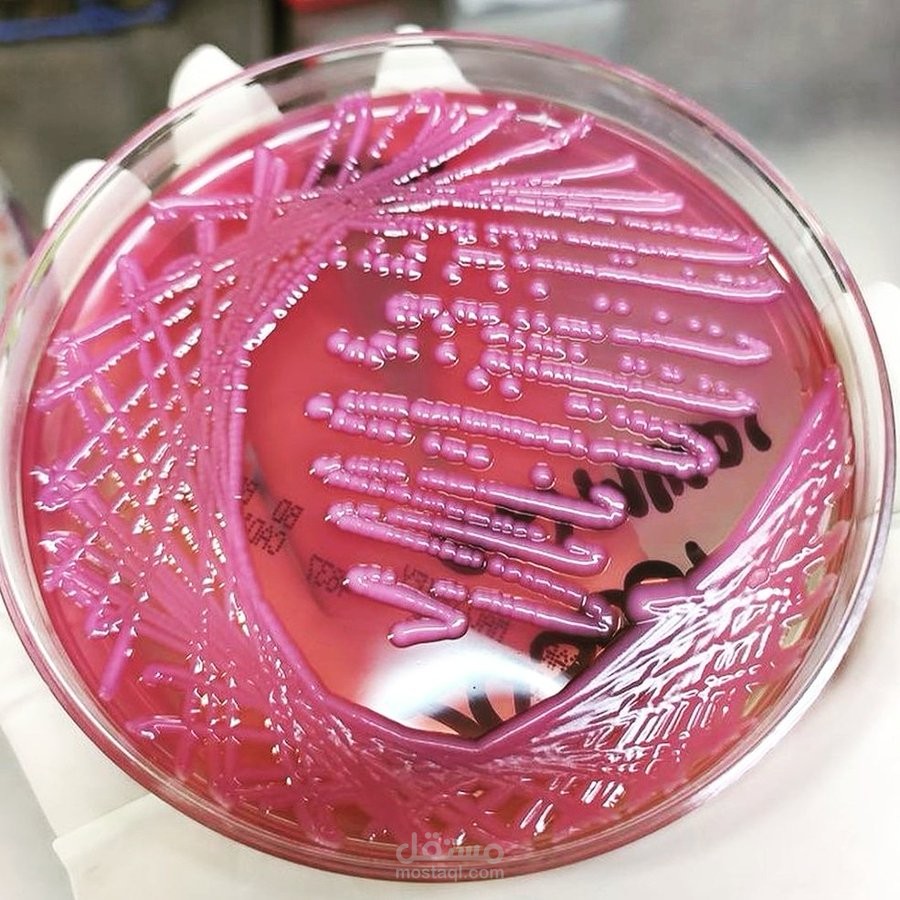
Klebsiella pneumoniae
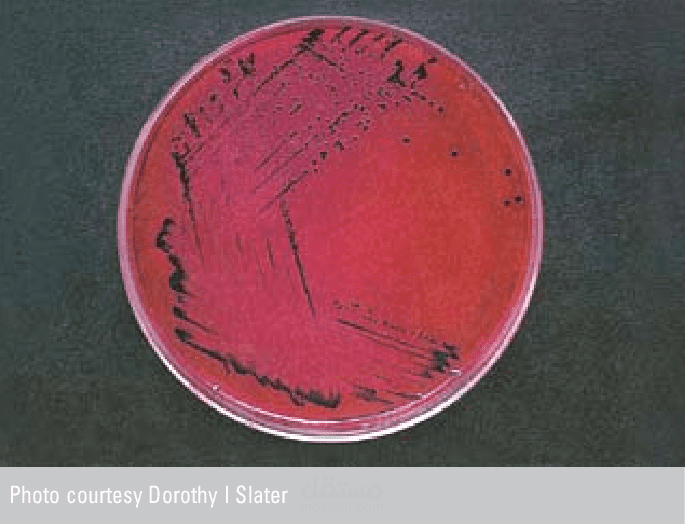
Salmonella enteritidis

May Z.
نبذة عني
طبيبه بيطريه أوائل الخريجين حاصله على دكتوراة ميكروبيولوجيا بكترولوجيا وفطريات كليه الطب البيطرى جامعه الإسكندرية ٢٠٢١؛ ماجستير ميكروبيولوجيا كليه الطب البيطرى جامعه الإسكندرية ٢٠١٦؛ دبلوم كيمياء حيوية جامعه الإسكندرية ٢٠٠٨؛ بكالوريوس العلوم الطبيه البيطرية جامعه الإسكندرية تقدير عام جيد جدا ٢٠٠٧؛أخصائي التحاليل الطبية تخصص كيمياء حيوية وبكتريولوجى ؛تخصص كتابه الابحاث الطبية والرسائل العلميه والمقالات والترجمه الطبيه ؛ حاصله على دورات متنوعه فى اللغه الانجليزيه